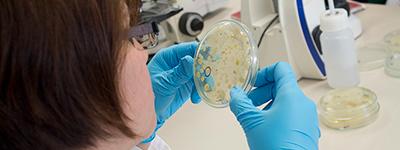

Bienvenidos a la Facultad de Ciencias Naturales e Ingeniería. En esta Facultad podrán encontrar una amplia diversidad de enfoques con multiplicidad de énfasis temáticos en aspectos de la ciencia, la tecnología y el cuidado por el ambiente.
Estamos comprometidos con el mejoramiento de nuestros conocimientos y capacidades para propiciar el desarrollo competente, crítico y ético de nuestros estudiantes. Las investigaciones que adelantamos buscan traducirse en aportes para la sociedad.